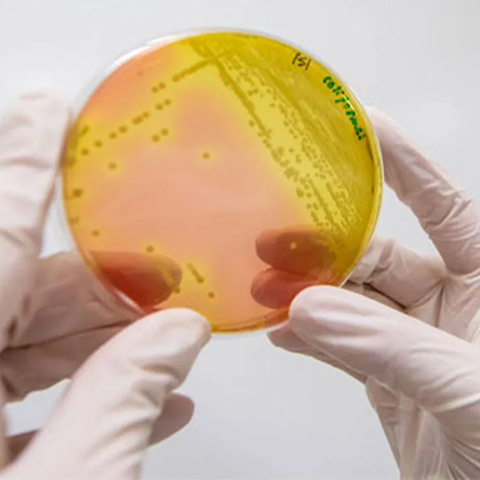

Objetivos de Investigación
El presente estudio tiene como objetivo central evaluar el impacto a distintos niveles que tiene la colonización intestinal por Bacterias Resistentes a los Antimicrobianos (BRA) en sujetos hospitalizados en centros de salud terciaria o en residentes de una comuna agrícola de Chile central.7 La hipótesis subyacente es que los sujetos portadores de BRA (i.e., colonizados) presentan un riesgo mayor de presentar infecciones clínicamente relevantes causadas por BRA, e incurren en mayores costos económicos personales y sociales, comparado con personas que no portan BRA. Esperamos generar evidencia de alta calidad para definir si las estrategias de vigilancia de RAM deben incluir evaluaciones de portación de BRA en su abanico de recomendaciones.
Objetivo General
1. Evaluar el impacto clínico y económico de la colonización intestinal por BRA en participantes hospitalizados y residentes de una comunidad agrícola de Chile central.
Objetivo Específico
1. Evaluar la prevalencia de colonización intestinal y su impacto en diferentes desenlaces en 5 hospitales terciarios chilenos.
2. Evaluar la carga de colonización intestinal y su impacto en diferentes desenlaces en 2 hospitales terciarios chilenos.
3. Determinar el riesgo de presentar colonización intestinal por BRA en residentes de la comuna de Molina que consultan por síntomas de infección del tracto urinario.
